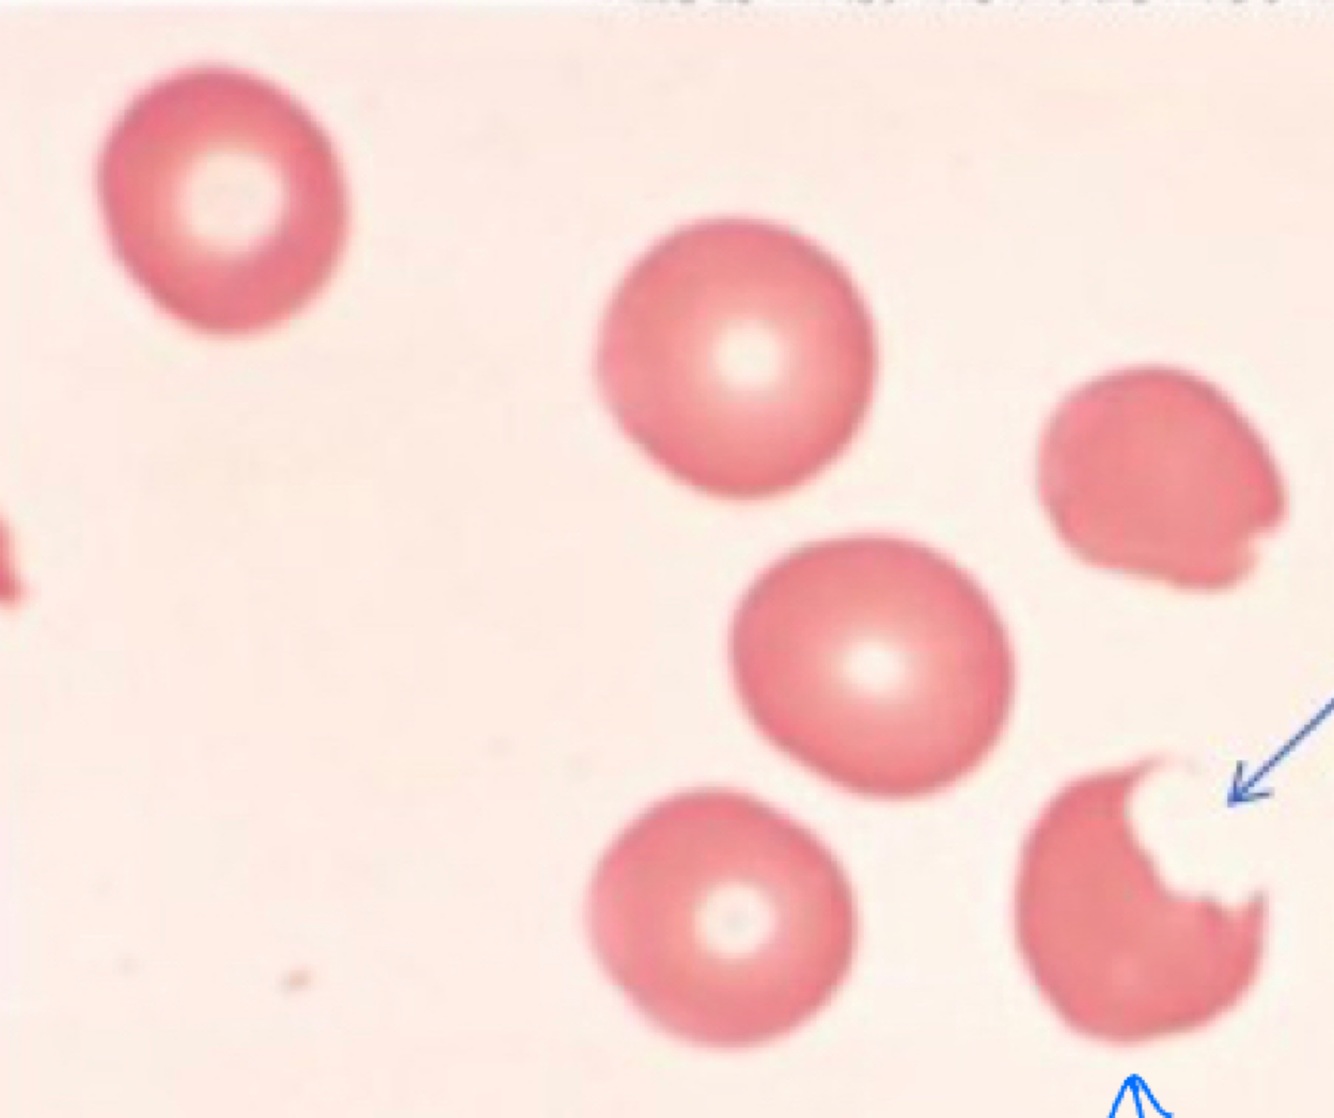

How does bacteria produce/get ATP
Glycolysis
How does glycolysis work
Breaks down glucose to form ATP
Glucose breaks bonds to create energy
How many ATP does glycolysis make
4
How many ATP does the Kreb’s cycle make
34-38
Describe the embden-meyerhof pathway

What does the hexose monophosphate pathway divert
Diverts glucose-6-phosphate (G6P) to pentose phosphate by the action of glucose - 6-phosphate dehydrogenase (G6PD)

What is the most common RBC enzyme deficiency
G6PD
What are Heinz bodies
Only seen w/ a Supra vital stain ‘
Oxidized hemoglobin that precipitated
Tells you hemoglobin is oxidized by stain image
Yellow/gold cells with little blue dots
What is a degmacyte
Aka bite cell
Seen with Wright stain
If seen = presence of Heinz bodies
Looks like a bite was taken out of it (different from a schistocyte)
Degmacytes (bite cell)

Heinz bodies
What is the hemoglobin to iron ratio
Each hemoglobin molecule = 4 iron
What is reduced iron called
Ferrous iron
What is oxidized iron called
Ferric iron
When hemoglobin is in its reduced form it can bind to
Oxygen
Oxygen cannot bind to
Methemoglobin
What is need to go back from Fe^3+ —> Fe^2+
NADPH methemoglobin reductase
Describe the methemglobinemia mechanism

What is hemoglobin M
A rare dominant hereditary disorder where glutamate replaces valine in position 67 on the beta chain of the hemoglobin molecule. This causes a permanently increased level of methemoglobin ranging between 15-30%. Patients are cyanotic
Describe the rapoport-luebering pathway

What is the significance of 2,3-BPG
Lets go of O2
Oxyhaemoglobin —> deoxyhaemoglobin
Name 2 characteristics of the RBC membrane
More elastic than a rubber band
More resilient than steel
What creates the membrane barrier and what can more through it
Phospholipid bilayer
Allows hydrophobic
What cannot pass the membrane
Ions with charge


